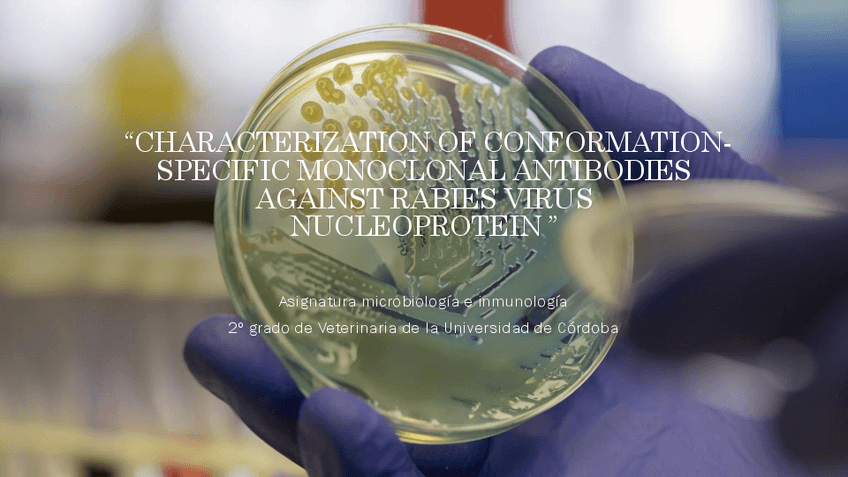

@Maesalro
Bio: Vendo también libros de la carrera!!
55 Publicaciones
2.79k Interacciones
1 Seguidores
1 Siguiendo
Lista de publicaciones de Maesalro
He publicado nuevos apuntes de 5º Economía de la Producción Ganadera: Preguntas-clave.pdf
He publicado nuevos apuntes de 5º Economía de la Producción Ganadera: Apuntes-Samuelson-y-presentaciones-Tema-1-al-4.pdf
He publicado nuevos ejercicios de 5º Economía de la Producción Ganadera: Recopilacion-problemas.pdf
He publicado nuevos examenes de 4º Patología Quirúrgica: Examen-parcial-quirurgica-grandes-animales-2023.pdf
He publicado nuevos examenes de 1º Etnología, Etología y Bienestar Animal: Examen-etnologia-2019.pdf
He publicado nuevos examenes de 4º Inspección y Control Alimentario: control-de-clase-inspeccion.pdf
He publicado nuevos trabajos de 3º Enfermedades Infecciosas: Presentacion-Diarrea-Virica-Bovina.pdf
He publicado nuevos trabajos de 2º Microbiología e Inmunología: Trabajo-practicas.pdf
He publicado nuevos trabajos de 2º Microbiología e Inmunología: Trabajo-caso-clinico-rabia.pdf
He publicado nuevos trabajos de 2º Microbiología e Inmunología: Poster-resolucion-caso-practicas.pdf
He publicado nuevos apuntes de 3º Propedéutica Clínica: Apuntes-rumiantes.pdf
He publicado nuevos trabajos de 2º Patología General: trabajo-investigacion.pdf
He publicado nuevos apuntes de 2º Neuroanatomía y Anatomía Topográfica: Trabajo-piel.pdf
He publicado nuevos examenes de 2º Anatomía Patológica General: Examen-mscro.pdf
He publicado nuevos examenes de 2º Anatomía Patológica General: Examen-macro.pdf
He publicado nuevos trabajos de 2º Anatomía Patológica General: Trabajo-descripciones-macroscopicas.pdf
He publicado nuevos practicas de 4º Inspección y Control Alimentario: Test-Huevos.pdf
He publicado nuevos trabajos de 4º Inspección y Control Alimentario: Actividad-tema-1.pdf
examenes
-
Autoevaluación
He publicado nuevos examenes de 5º Nutrición y Alimentación Animal: Autoevaluación
He publicado nuevos apuntes de 1º Embriología: Fecundacion-hetero-parental-perros.pdf